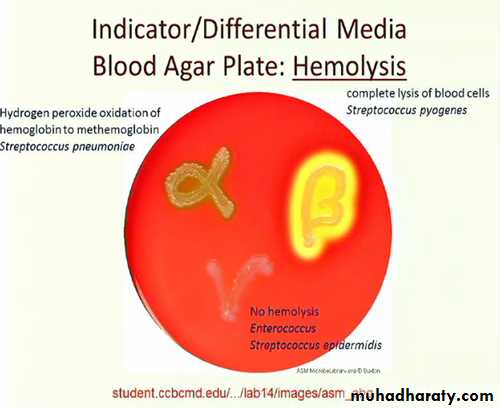
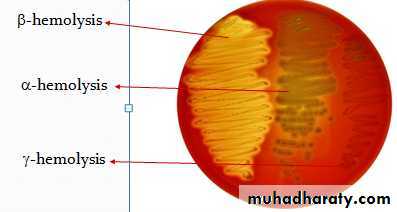
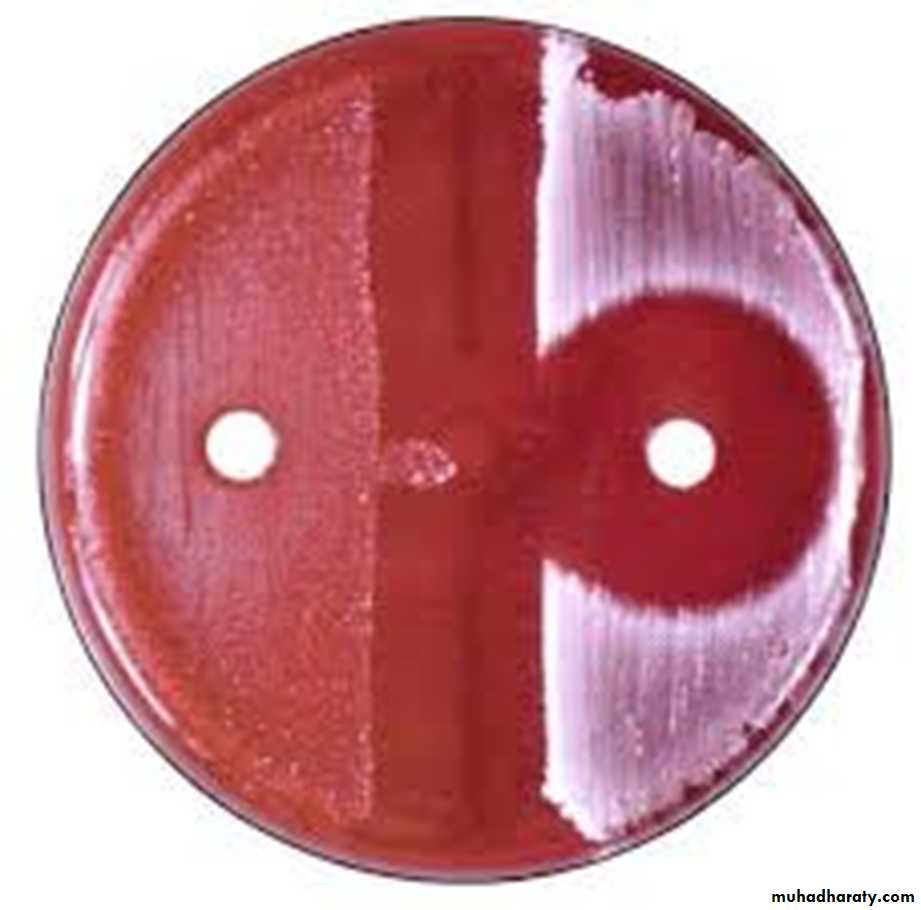
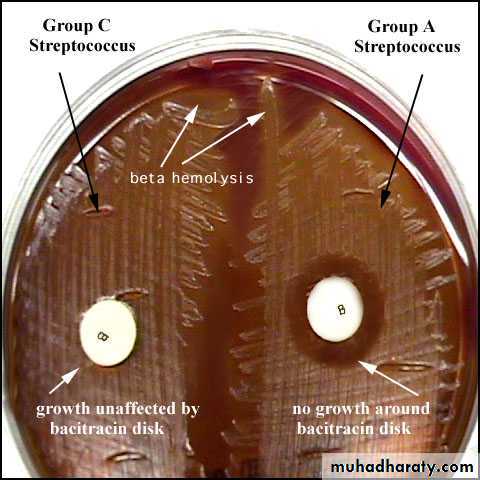

• Systimatic bacteriology
• D. Faten naeem abbas• Gram positive cocci bacteria
• Genus Streptococcus• General Characteristic:
• Gram-positive cocci,• Non motile
• non spore forming
• arranged mostly in chains or in pairs.
• Most species are facultative anaerobes, few are obligatory anaerobic.
• Some of streptococci are encapsulated
• Streptococci (catalase –ve) while, Staphylococci (catalase +ve)
• Fastidious microorganism (require rich media for its growth with additional growth supplement). Such as Blood Agar and Chocolate Agar (enrich media)
•
• Classify System :
• Streptococci heterogeneous group and no one system suffices classify. System use to classification depend on:• Colony Growth Characteristic,
• Type of Hemolysis,
• Antigenic composition of group
• Specific cell-wall substances,
• Biochemical properties or clinical appearances
• Antigenic composition of the capsular polysaccharide (like Str. pneumonia).
• Molecular genetics
• I. Hemolytic activity:
• The initial classification of the Strep. depends on the type of hemolysis produced on blood agar (under anaerobic conditions about 5-10 % Co2):• β-hemolysis: complete RBCs destruction Clear zone around the colony (called target sign). S. pyogenes, S. agalactiae
• α-hemolysis: partial RBCs destruction Greenish discoloration of agar. S.pneumoniae, Viridans streptococci
• γ- hemolysis: No clear changes around the colony (No hemolysis). Enterococci and non-enterococcal streptococci S.bovis).
A B C
• Serological classification (Lancefield classification):
• The cell wall of bacteria (e.g, Streptococci) is make from peptidoglycan that composed of repeating units of N-acetylglucosamine and Nacetylmuramic acid.• Streptococci identified based on the serologic reactivity of "cell wall" polysaccharide antigens described by Lancefield classification.
• The presence of polysaccharide antigen called "C-substance" or "C-carbohydrate" present in the cell wall which differ from group to another. Depending to these specific polysaccharide antigens, Streptococci named as groups (group specific) from A to U (more than 20 serogroups).
• Groups A, B, C, D, and G are most commonly associated with human disease
• Viridans streptococci and Streptococcus pneumoniae have no group-specific antigen
• Groups of Streptococci:
Although there are more than 30 species of streptococci, only 5 are significant human pathogens. Three of these pathogens have Lancefield antigens: Lancefield group A, B and D. The other two pathogenic species of the streptococcal genus do not have Lancefield antigens, and are therefore just called by their species names: One is Streptococcus pneumoniae and the other is actually a large group of streptococci collectively called the Viridans group.• Groupable Streptococci
• Group A: Streptococcus pyogenes• primary important pathogen for human cause infections, (respiratory system, systemic and skin).
• Group A are usually bacitracin sensitive
Group B: Streptococcus agalactiae
• endogenous to the vaginal mucosa and been responsible for puerperal fever, fatal neonatal meningitis and endocarditis.
• This group is rarely bacitracin sensitive.
Differentiation between -hemolytic Streptococci
The following tests can be used to differentiate between -hemolytic Streptococci
• Lanciefield Classification.
• Bacitracin susceptibility Test Specific for S. pyogenes (Group A).
• CAMP test Specific for S. agalactiae (Group B).
Group C and G: Strep. equisimilis and Strep.equi
Causes erysipelas, puerperal fever, throat infection, sinusitis bacteremia or endocarditis, occur sometimes in pharynx and produce β hemolysin on sheep blood agarGroup D:
Includes Enterococci(Strep. Faecalis) and non-Enterococci (Strep. bovis) produces α and γ hemolysin which may causes UTI or endocarditis.
Group E, F, H and K, U
Occur primarily in animals others can infect humans.
B- Non groupable Streptococci
These usually produce α-hemolysis or no hemolysis on blood agar. This group includes:1- Strep. pneumoniae (pneumococci)
• 2- Strep. viridans
• Can difference between group species as in table:
Differences
Str. viridans
Str. pneumonia
Bile solubility
insoluble
soluble
Inulin fer.
not fermented
fermented
Res. to optochin
resist
not resistant
Quelling reaction
negative
positive
Pathogenicity
no path.
fatal septicemia to mouse
• C- Peptostreptococci
• They are members of the normal flora of the gut and female genital tract, grow under aerobic or microaerophilic condition and produce variable hemolysis.Chemical structure and antigens
• Cell wall polysaccharide C
• Peptidoglycan• Lipoteichoic acid
• M-protein
• T substance and R protein
• Capsule
• F protein
• Antigenic Structure
• Hemolytic str. can be divided into serologic group (A-H,K-U), certain groups can be subdivided into types, antigenic substances are:• 1- group specific cell wall antigen: which is CHO, it is Lancefield groups (A-H,K-U), act as toxigenic factor and antigenic factor.
• 2- M- protein:
• When M protein is present, the streptococci are virulent,
• It able to resist phagocytosis by polymorphonuclear leukocytes.
• M protein also promotes adherence to host epithelial cells.
• Resistant to heat and acid
• Trypsin Sensitive
• 3- T-substance:
• not virulence factor, act as colonizing and antigenic factor• It is obtained from streptococci by proteolysis digestion.
• T substance permits differentiation of certain types of streptococci by agglutination with specific antisera
• acid-labile and heat-labile.
• Resistant to trypsin
• 4- R-protein: also act as colonizing and antigenic factor
• 5- Nucleoprotein: antigenic factor
• 6- Lipoteichoic Acid
• 7- Capsular Polysaccharide:
• -Hyaluronic acid
• -Not present in all strains
• -Same as host hyaluronic acid (cartilage, skin etc(
• -Non immunogenic
• -Antiphagocytic
•
• Group A beta -Hemolytic Streptococci (GABH)
Streptococcus pyogenes• These organisms are so-named because they possess the Lancefield group A antigen
• They are beta-hemolytic on blood agar.
• They are also called Streptococcus pyogenes (which means pus-producing).
• The components of the streptococcal cell wall that are antigenic include: C carbohydrate & M protein (~80 types(
• Pathogenesis and Virulence Factors:
• It is a major success pathogen to its ability to colonize, rapidly multiply and spread in host while avoiding phagocytosis and confusing the immune system. It is found usually in the respiratory tract, without signs of disease.• Strep. pyogenes can infect when defenses are compromised or when its able to penetrate the constitutive defenses.
• Strep. pyogenes produces a wide group of virulence factors, include:
• Toxins:
(1)Protein M is a major virulence factor for the group A streptococcus. it’s a hair like projections of streptococcal cell wall. It inhibits the activation of complement and protects the organism from phagocytosis. However, it is also the weakest point in the organism's defense, because plasma cells generate antibodies against the M protein. These antibodies bind to the M protein (opsonization), aiding in the destruction of the organism by macrophages and neutrophils.
• (2)Hyaluronic acid capsule (non antigenic) as an immunological cover and to inhibit or prevent opsonized phagocytosis by neutrophils or macrophages.
• Hyaluronidase splits hyaluronic acid(an important component of the ground substance of connective tissues). Thus, hyaluronidase aids in spreading of infecting microorganisms (spreading factor). Hyaluronidases are antigenic and specific for each bacterial or tissue source.
• (3) Streptolysin O: The O stands for oxygen labile as it is inactivated by oxygen. This enzyme destroys red and white blood cells and is the reason for beta-hemolytic ability. This enzyme is also antigenic (activates the proteolysis enzyme plasmin, which breaks up fibrin blood clots).
• (4) Streptolysin S: The S stands for oxygen stabile. This is also responsible for beta-hemolysis but is not antigenic.
(5) Exotoxins, such as pyrogenic (erythrogenic) toxin
• This toxin is soluble and it is destroyed by boiling for 1 hour.• Only S. pyogenes strains elaborating this toxin, can causes the rash in scarlet fever and systemic toxic shock syndrome. A non-toxigenic strain, after lysogenic conversion will produce erythrogenic toxin.
• Erythrogenic toxin is antigenic (Super antigen).
•
• Enzymes:
• Nucleases: Four antigenic types (A,B,C,D(• Facilitate liquefactions of pus
• Nucleases A, C have DNase activity
• Nucleases B, D also have RNase activity
• DNAase (streptodornase- 4 types)
• Streptococcal deoxyribonuclease depolymerizes DNA. The enzymatic activity can be measured by the decrease in viscosity of known DNA solutions.
• Streptokinase (spreading factor). Streptokinase is produced by many strains of group A beta-hemolytic streptococci. It transforms the plasminogen of human plasma into plasmin, an active proteolytic enzyme that digests fibrin and other proteins. Streptokinase has been given intravenously for treatment of pulmonary and of coronary artery and venous thrombosis.
• C5a Peptidase: C5a avoidance of phagocytosis; enhances chemotaxis of phagocytes
• Hyaluronidase: hydrolyzes hyaluronic acid
• Others: Proteinase, NADase, ATPase, phosphatase, etc.
Diseases:
• I. Local infections: (non-invasion more common and less severe)
• Sore throat (acute pharyngitis, pharyngo tonsillitis) S. pyogenes is the leading cause of pharyngitis (strep throat). It is acquired by inhaling aerosols by infected individuals. The symptoms reflect the inflammatory events at the site of infection. sinusitis, otitis, and pneumonia.
• 2- Impetigo (superficial) infection of epidermal layers of skin.
• 3-Cellulitis (deep) occurs when the infection spreads subcutaneous tissues.
• 4- Erysipelas (erythema on face): Acute superficial cellulitis of skin with lymphatic involvement; face and lower extremities, skin and subcutaneous tissues
II. Systemic infections: (invasion &/or toxin) (more severe and less common). This occurs when the bacterium is able to infect areas where it is not usually found, such as the blood and the organs. Invasive, toxigenic streptococci cause joint or bone infections, and myositis, meningitis and endocarditis, Bacteremia.
• Toxic shock syndrome; caused by a few strains that produce a toxic shock toxin (Super antigens).
• Necrotizing fasciitis (destructive wound infections) infection of the fascia & may proceed rapidly to underlying muscle. It is severe invasive infections, prompting descriptions of "flesh eating bacteria".
• Scarlet fever (rash); a severe complication of streptococcal infection, but now, because of antibiotic therapy, it is little more than streptococcal pharyngitis accompanied by rash. It caused by erythrogenic toxin.
III. Post streptococcal infection sequel: (delayed antibody mediated diseases): it is a non-suppurative complications
1- Rheumatic fever (after sore throat): type II hypersensitivity
2- Acute glomerulonephritis (after skin or pharynx infection) : type III hypersensitivity
• Two post streptococcal sequel rheumatic fever & glomerulonephritis, may follow streptococcal disease, and occur in 1-3% of untreated infections. Due to immunological reactions to Strep. pyogenes antigens. Some of the antibodies produced during the above infections cross-react with certain host tissues. These can indirectly damage host tissues after the organisms cause non suppurative complications.
• Lab Diagnosis for S.pyogenes:
Specimens: depend on the nature of infection, e.g. sputum, throat swab, nasopharyngeal swab, blood, CSF…etc. Gram stain: G+ve cocci, arrange in chains.
Culture:
• on blood agar under 5-10%CO2 pinpointed, Grayish white, translucent, matte or glossy colonies with large zone of β- hemolysis.
Sensitive to Bacitracin disc (0.04 U), causes zone of growth inhibition more than 15mm.
PYR +ve: rapid test, pink is positive.
Serology:
1)The rapid strep test (ELISA-based),
2) Lancefield grouping,
3) M-protein serotyping
4) ASO test: Ab Titer: Normal < 200 > significance result
PYR (Pyrrolidonyl Aminopeptidase)
Test is used for the detection of pyrolidonyl arylamidase (also called pyrrolidonyl aminopeptidase) activity in Streptococcus pyogenes (group A strep),It is also known as PYR (L-pyrrolidonyl-β-naphthylamide) which serve as a substrate for the detection of pyrrolidonyl peptidase.
• ASO test:
• Streptolysin O is a protein that is hemolytically active in thereduced state but rapidly inactivated in the presence of oxygen its antigenic and combines quantitively with antistreptolysin O (ASO) this antibody inhibited hemolysis by streptolysin O.• Streptolysin O +RBCs = hemolysis
• Streptolysin O+ASO+ RBCs = no hemolysis.
• Measure Ab against Streptolysin O,
• ASO test used in suspected case of rheumatic fever.
• This test used to determine significance of current streptococcal infection by measuring the ASOT:
• ASOT Ab Titer): Normal < 200 > abnormal).
•
Group B beta -Hemolytic Streptococci (S. agalactiae )
Beat hemolyticLancefield group B
They are members of the normal flora of the female genital tract vagina in 5-25% of woman and in urethral mucous membranes of male carriers as well as in the G.I.T.
It can transfer from infected mothers to infants at birth and may cause:
(1) meningitis and septicemia in neonates with high mortality rate,
(2) endocarditis
(3) septicemia or pneumonia in impaired immune systems individuals .
(4) diabetic foot infections.
Pathogenesis: Capsule, hemolysin and cAMP factor
• Lab. Identification :
Their colonies on blood agar are larger and less hemolysis than Group ABased on their resistance to antibiotics it can be concluded that ampicillin in combination with gentamicin gentamicin/netilmicin is first choice course of therapy
Strep. group B resistant for bacitracin .
cAMP test-positive:
The CAMP factor produced by GBS acts synergistically with the staphylococcal β-hemolysin inducing enhanced hemolysis of sheep erythrocytes. Organism produces definitive arrow when close to Staphylococcus aureus.
CAMP Test
• CAMP Test was first discovered by four researchers Christie, Atkins, Munch, and Peterson in 1944, that’s why this test is also known as Christie–Atkins–Munch-Peterson test.• CAMP test is used to identify Streptococcus agalactiae from other Group B β-hemolytic streptococci. They form a substance called CAMP factor which enlarges the area of hemolysis formed by the β-hemolysin elaborated from Staphylococcus aureus.
• The CAMP test mainly recognizes the CAMP factor which is a diffusible, heat-stable, extracellular protein produced by Group B Streptococcus that enhances the hemolysis of sheep erythrocytes by Staphylococcus aureus. The CAMP factor acts synergistically with the beta hemolysin produced by S. aureus to induce enhanced hemolysis of sheep or bovine RBCs but not human, rabbit or horse RBCs.